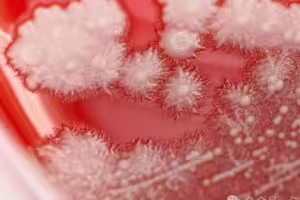
感冒秒吞抗生素!36歲男喉嚨痛 一照「長滿雪花」醫嚇愣 感冒秒吞抗生素!36歲男喉嚨痛 一照「長滿雪花」醫嚇愣

常說父母的愛非常偉大,往往在為人父母後才懂那份為孩子無私付出的真心,然後看到孩子忤逆自己時才知道以前有多不孝w 相信不少人認識首圖這位老爸,坦白說這位爸爸蠻紅的,儼然已成為打卡勝地的他可說是素人明星!一個簡單的揮手動作讓他格外不同,當然最大的賣點也來自一身裝扮,是什麼原因讓他開始這樣做,做到最後讓孩子乾脆求饒爸爸別再這樣了w
一切故事都要從這位不肖子Dale開始說起(指)
雖然用不肖子稱呼他但Dale也不是真做了什麼大逆不到的事情,Dale只是做了每一位青春期孩子都會有的行為w Dale的爸爸Rain每天都會送Dale搭車上學,看到兒子上車後會在家門前跟Dale揮手說拜拜,這行為讓Dale的同學忍不住開完笑說哎唷你爸爸好疼你♥ 雖然父子感情好是好事,但你也知道的,對青春期孩子來說總希望展現獨立、帥氣一面,在這樣的想法下就會覺得爸爸這行為好丟臉喔~於是Dale就跟媽媽說以後別讓爸爸這樣做了,很丟臉捏!
想當然爸爸聽到後超美送,想說林盃這麼疼你你竟然嫌我丟臉!賀阿,哩災戲!
7pupu的爸爸就暗自做了一個決定,既然你越不想要我這麼做我越要這麼做!怕丟臉?沒關係,我就讓你丟臉到底!
於是
從那天起爸爸開始以不同造型出現在家門前跟Dale說Bye bye wwww
兒子拜拜
路上小心唷~
記得想念爸爸唷♥
是的,Rain開始以不同裝扮出現在家門前,想當然這畫面不只Dale看到,就連車上的同學、司機甚至附近鄰居都看的到w 很快的Rain就成為當地的網紅,大家開始期待明天會看到什麼裝扮,總不會讓大家失望的Rain都會在登場時把眾人逗樂!
阿,除了他兒子(≧∀≦)ゞ
這對父子的故事很快就被媒體報導出來,甚至上節目暢談「爸爸復仇記」(笑),網友紛紛大讚Rain是一位聰明的父親,知道怎麼化解孩子青春期的情緒與叛逆,以如此歡樂的結果應對Dale當初那句話。而Dale也沒想到事情會演變成這樣,既然是自己開頭的也只能......認了w